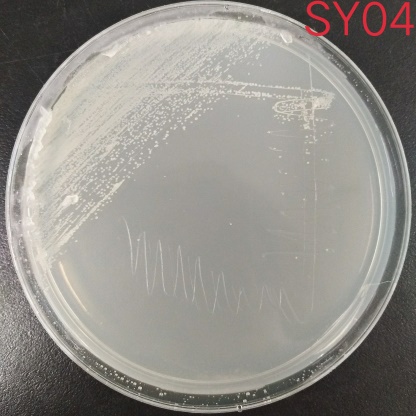
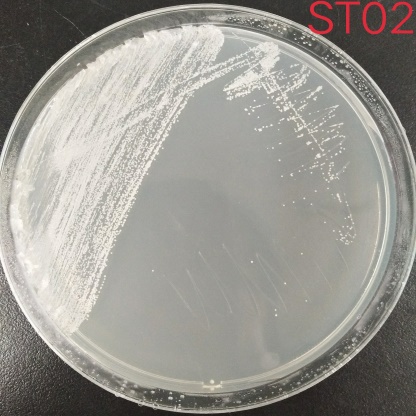
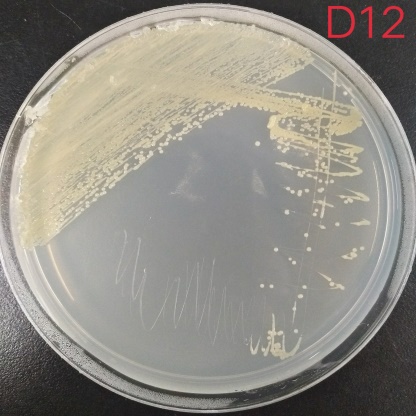
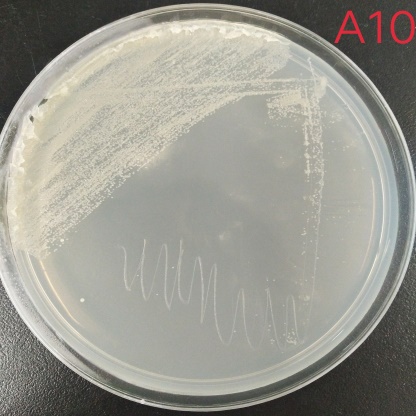
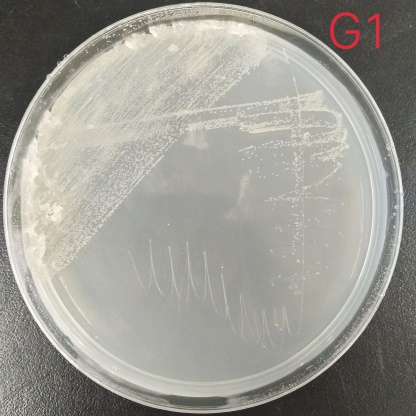

嗜盐菌菌种鉴定与抗逆性能研究毕业论文
2020-04-16 16:43:48
摘 要
嗜盐菌由于其特殊的结构特点和理化性质,使得它被广泛应用于发酵、污水处理、多聚化合物的生产、食品工业、生物电子和转基因植物的培育等方面。本课题对从新疆分离的五种嗜盐菌菌株进行菌属鉴定,对其菌落形态、生长特性、最适生长条件如:盐浓度、pH、温度等进行优化,并对耐盐性、pH耐受性以及温度耐受性等抗逆性进行考察,为进一步的研究奠定基础。经过16S rRNA序列同源性对比后确定分离得到的菌株中,有一株为杆菌,有芽孢;一株为葡萄球菌;另外三株均为盐单胞菌。从实验结果来看,五株菌最适NaCl浓度均为0.5 M,都属于中度嗜盐菌。SY04和ST02生长最佳时对应的pH是6.0,D12、A10、G1最适pH分别是8.0、9.0、7.0。SY04、ST02、A10这三个菌株在25℃生长旺盛,而D12与G1最适温度是30℃。
关键词:嗜盐菌 菌种鉴定 抗逆性
Abstract
Due to its special structural characteristics and physicochemical properties, halophilic bacteria are widely used in fermentation, sewage treatment, production of multi-polymer compounds, food industry, bio-electronics and cultivation of transgenic plants. This study identified the genus of five halophilic strains isolated from Xinjiang, and optimized their colony morphology, growth characteristics, optimum growth conditions such as salt concentration, pH, temperature, etc., and tolerance to salt tolerance and pH. Resilience to stress and temperature tolerance is investigated to lay the foundation for further research. After 16S rRNA sequence homology comparison, one of the isolated strains was identified as Bacillus sp., one spore; one strain was Staphylococcus; the other three strains were S. monocytogenes. According to the experimental results, the optimum NaCl concentration of the five strains was 0.5 M, which belonged to moderate halophilic bacteria. When SY04 and ST02 were optimally grown, the corresponding pH was 6.0, and the optimum pH of D12, A10 and G1 were 8.0, 9.0, and 7.0, respectively. The three strains SY04, ST02 and A10 grew vigorously at 25 °C, while the optimum temperature for D12 and G1 was 30 °C.
Key words:Halophilic bacteria, strain identification, stress resistance.
目录
摘 要 I
Abstract II
第一章 文献综述 1
1.1 嗜盐菌 1
1.2 嗜盐菌嗜盐机理及特性 2
1.3 嗜盐菌的应用 3
1.3.1 食品加工方面的应用 3
1.3.2 酶工业上的应用 3
1.3.3 生物电子学上的应用 3
1.3.4 环境生物学上的应用 3
1.3.5 相容性溶质的应用 4
1.4 嗜盐菌的研究进展和研究前景 4
1.4.1 嗜盐菌的研究进展 4
1.4.2 嗜盐菌的研究前景 4
1.5 抗逆性 4
第二章 材料与方法 6
2.1 实验仪器和试剂 6
2.1.1 主要实验仪器 6
2.1.2 主要实验试剂 6
2.1.3 菌株 7
2.1.4 培养方法 7
2.2 实验方法 8
2.2.1 菌株的形态学鉴定 8
2.2.2 PCR扩增测定菌株的16S rRNA序列 8
2.2.3 生长曲线的测定 9
2.2.4 菌株能耐受的盐浓度范围测定 9
2.2.5 菌株能耐受的pH范围及最适值的确定 9
2.2.6 菌株能耐受的温度范围及最适值的确定 10
第三章 结果与讨论 11
3.1 菌株的形态学分析 11
3.2 菌株的序列测定与分析 13
3.3 生长曲线测定结果与分析 15
3.4 耐盐性的测定结果与分析 16
3.5 生长pH范围及最适值的测定结果与分析 17
3.6 生长温度范围及最适值的测定结果与分析 18
第四章 结论与展望 20
4.1 结论 20
4.2 展望 20
参考文献 21
致谢 23
第一章 文献综述
1.1 嗜盐菌
在高盐环境中能够生存的微生物可划分为三类:一类是能耐受一定浓度的盐溶液,但在无盐存在条件下生长最好的菌称为耐盐菌[1]。第二类是一定浓度的盐为菌体生长所必需,且在一定浓度的盐溶液中生长最好,称为嗜盐菌[1]。第三类是在盐浓度从0%~饱和盐溶液中均能生长且在一定浓度的盐溶液生长最好的菌种,叫多能盐生菌[1]。另一种分类方法根据不同微生物对盐浓度的耐受程度以及适应程度,可以把微生物分为:
表1-1 嗜盐微生物的分类[2]
以上是毕业论文大纲或资料介绍,该课题完整毕业论文、开题报告、任务书、程序设计、图纸设计等资料请添加微信获取,微信号:bysjorg。
相关图片展示:

您可能感兴趣的文章
- 布里奇果油纳米乳液在等渗运动饮料中应用的可行性外文翻译资料
- 茶多酚类作为呋喃抑制剂在美拉德模型系统和罐装咖啡模型的形成外文翻译资料
- 实用型重组杂交贻贝生物粘合剂fp-151外文翻译资料
- COI条形码在我国市场常见鱼类品种鉴定中的应用毕业论文
- DNA条形码在我国市场常见虾蟹品种鉴定中的应用毕业论文
- 基于SYBR-Green-I荧光定量PCR技术鉴定我国常见虾蟹品种方法的建立毕业论文
- 微型COI条形码在我国市场常见虾蟹类品种鉴定中的应用毕业论文
- 水稻体内敌草隆液相检测方法建立及外源茉莉酸对其在水稻体内代谢的影响毕业论文
- 蛋白饮料经高压静电处理后蛋白质的变化毕业论文
- 核酸茎环结构用于电化学快速检测肠毒素毕业论文


